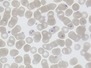

17 February 2012
Code-A-Chrome
After technicolour treatment the normal complement of 23 chromosome pairs from a human cell looks more like a clew of psychedelic glow worms. Composed of ordered lengths of DNA, each chromosome pair has a characteristic length and shape. Inherited genetic disorders and cancer can cause them to subtly or wildly distort. Fluorescence in situ hybridisation (FISH) colour-banding highlights a precise bar-code pattern shared by normal chromosome pairs, a boon for the cytogeneticists who match them up and check them. Can you see pairs? Fragmented gibbon DNA tagged with fluorescent dyes is here shown to bind specifically to regions of human DNA with a similar sequence. Juxtaposition of the dyes shows up as different colours under confocal microscopy producing a striped bar-code pattern. Where the pattern is disrupted, chromosomes have rearranged. This technique can be used to help diagnose certain diseases like leukaemia informing the appropriate choice of treatment.
Written by
- Fengtang Yang & Malcolm Ferguson-Smith
- Originally published under Creative Commons (CC-BY 2.0)
Search The Archive
Submit An Image
Like us on Facebook
Follow on Twitter
Follow on Tumblr
Follow on Instagram
What is BPoD?
BPoD stands for Biomedical Picture of the Day. Managed by the MRC Laboratory of Medical Sciences until Jul 2023, it is now run independently by a dedicated team of scientists and writers. The website aims to engage everyone, young and old, in the wonders of biology, and its influence on medicine. The ever-growing archive of more than 4000 research images documents over a decade of progress. Explore the collection and see what you discover. Images are kindly provided for inclusion on this website through the generosity of scientists across the globe.
BPoD is also available in Catalan at www.bpod.cat with translations by the University of Valencia.